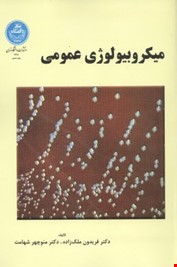
میکروبیولوژی عمومی (فریدون ملک زاده و منوچهر شهامت)

| وزن | 600.0 گرم |
|---|---|
| انتشارات | دانشگاه تهران |
| مولف | دکتر فریدون ملک زاده و دکتر منوچهر شهامت |
| موضوع | حقوق (زیست شناسی) |
| شابک | 9789640348697 |
| قطع | وزیری |
| جلد | سخت |
| بارکد | 9789640348697 |
- کتاب مِنگان 07136665260 /
- فروشگاه /
- علوم کشاورزی /
- میکروبیولوژی عمومی (فریدون ملک زاده و منوچهر شهامت)
میکروبیولوژی عمومی (فریدون ملک زاده و منوچهر شهامت)
در انبار موجود نمی باشد
میکروبیولوژی عمومی (فریدون ملک زاده و منوچهر شهامت)
موجود در انبار
دیدگاه خود را در باره این کالا بیان کنید
افزودن دیدگاه
دیدگاهها
هیچ دیدگاهی برای این محصول نوشته نشده است.
هیچ پرسش و پاسخی ثبت نشده است.
پرسش خود را درباره این کالا بیان کنید
ثبت پرسش
انصراف
ثبت پرسش




0دیدگاه کاربران